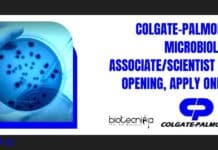
Colgate-Palmolive Microbiology Associate/Scientist Job Opening, Apply Online Colgate-Palmolive Microbiology Associate

Thomson Reuters Hiring Biotech / Biochem Candidates | Apply Now
Build a career without boundaries. Do work that matters, with the flexibility to pursue your passion wherever it leads. Bring your ambition to make...
CDRI AWARDS for Excellence in Drug Research – Apply Now
CDRI AWARDS for Excellence in Drug Research
Instituted by the CSIR-Central Drug Research Institute, Lucknow – 226 031
Invitation for Nominations / Applications
Preamble : CSIR-Central Drug...
Major Breakthrough : Successful 3D Printed Blood Vessel Transplant In Monkey – A First...
Scientists at the Chinese Biotech company Revotek, announced recently that the team has successfully transplanted 3-D-printed blood vessels into the rhesus monkey and have...
Cashmere Goat : First Cloned Goat with Cashmere Wool Born in China
Years after the breakthorugh that was Dolly the sheep, now comes news from north China's Inner Mongolia Autonomous Region, that the world's first cloned goat...
Baxter to Acquire Claris Injectables to Expand Portfolio of Essential Generic Injectable Medicines
Acquisition Adds Global Portfolio of Sterile Injectables, Robust Pipeline, and Manufacturing Capabilities
Accelerates Baxter’s Strategy to Become a Global Leader in the Injectable...
JRF Position in SERB Project @ INST, Mohali | Attend Walk-In-Interview
Walk-In-Interview will be conducted in Institute of Nano Science and Technology, Mohali, on January 16th 2017 at 11.00 am to select one JRF in...
Govt Job : 31 R&D Openings as Consultant (Epidemiologist) @ West Bengal State Health...
West Bengal State Health & Family Welfare Samiti Swasthya Bhawan, Wing-'B', 3rd Floor
GN-29, Sector-V, Bidhannagar
Kolkata - 700091
West Bengal State Health & Family...
Biological Science Candidates Work as Regulatory Affairs Specialist @ PPD, Gurgaon/Delhi
PPD is a leading global contract research organization providing comprehensive, integrated drug development, laboratory and lifecycle management services. Our clients and partners include pharmaceutical,...
Appointment For the Post of Assistant Professor in Biotech @ Vinoba Bhave University
Vinoba Bhave University was established in the year 1992 with it’s headquarter at Hazaribag, the divisional headquarter of North Chhotanagpur division of the state...
Freshers Job : Trainee scientific Officer – Production Post Vacant @ Panacea Biotec
Panacea Biotec is a leading research based Health Management Company. We are engaged in research, development, manufacture & marketing of Vaccines, Bio-Pharmaceuticals and Pharmaceuticals...
Life Science & Microbiology- Professor / Associate / Assistant Professor Vacancy @ CUTN
CENTRAL UNIVERSITY OF TAMIL NADU
(Established by an Act of Parliament, 2009)
Employment Notice No. CUTN/T/04/2016
CUTN invites Online applications from the eligible candidates for the following...
TIFR – Visiting Students’ Research Programme (VSRP-2017)
The Visiting Students' Research Programme (VSRP-2017) will be held at TIFR, Mumbai during the period May 8 to July 5, 2017.
Tata Institute of Fundamental...
Apply for Postdoctoral Position @ IIT Indore | Earn Upto Rs 40,000/- pm
Advertisement for a Postdoctoral Position
Applications are invited from motivated and interdisciplinary candidates for a postdoctoral position in the research project “Development of Nanomaterial...
Opportunity to Work as Biostatistician @ GSK | Apply Online
GSK is a science-led global healthcare company with a mission to help people do more, feel better, live longer. At GSK, we research, manufacture...
Manipal University Hiring For JRF Post in Dental Pulp Stem Cells Project
Applications are invited for the Junior Research Fellow and Lab Assistant position for the following DBT funded projects under the supervision of Dr. Anandh...